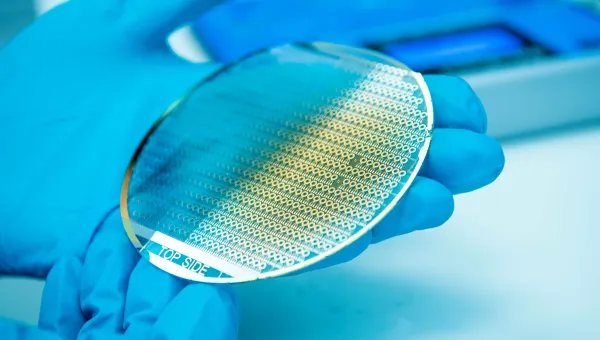
Pair of gloved hands holding a silicon disc chip

Breadcrumb
Research centre
Centre for Internet of Things and Pervasive Systems
We bring together researchers who are creating the future of internet of things and pervasive systems, from underpinning semiconductor and sensor devices, machine intelligence and data science, through to new application domains.
Part of
Child page cards
-

About us
The Centre is a hub for IoT research and education in the School of Electronics and Computer Science. -

Research areas and application domains
Discover how our fundamental research is unlocking the potential of IoT and its real-world applications. -

Our people
Find out more about our management group, including research interests and contact details. -

Projects
Find out more about our research projects. -

Publications
Browse our publications catalogue to learn about our research. -

Join us
Learn how to engage with the Centre by finding out more about our activities, doing a PhD with us, or working with us. -

News and events
Explore our latest news and upcoming events, including talks and seminars.

At the C-IoT, we are shaping the evolution from connected devices to connected intelligence — building networked systems that sense, learn, communicate, and act together to serve the society.
Abdulkadir Çelik
Associate Professor. Head of C-IoT

A significant proportion of the predicted billions of IoT devices will be battery powered. My research considers how these can last longer and do more.

Like a work of art, data has history: how it was created, processed, and stored. Knowing this gives greater understanding of how to use it.

We’re exploring how to create the IoT ‘tap’ of the future, and how to allow people to observe flows in a trustworthy and reliable way.
Connect with us
-
Study
- View all courses
- Taught postgraduate study
- Pre-sessional English courses
-
Subjects
- Acoustical engineering
- Aeronautical and astronautical engineering
- Ageing and gerontology
- Archaeology
- Art, design and fashion
- Audiology
- Biological sciences
- Biomedical and medical engineering
- Business, accounting, finance and marketing
- Chemistry
- Civil engineering
- Computer science and software engineering
- Economics
- Education
- Electrical and electronic engineering
- English
- Film studies
- French
- Geography and environmental science
- History
- Languages and linguistics
- Law
- Maritime engineering
- Mathematical sciences
- Mechanical engineering
- Medicine
- Music
- Nursing, midwifery and healthcare
- Ocean and Earth science
- Philosophy
- Photonics and optoelectronics
- Physics and astronomy
- Politics and international relations
- Psychology
- Social statistics and demography
- Sociology, social policy and criminology
-
PhDs and research degrees
- Create your own research project
-
Find a PhD project
- A missing link between continental shelves and the deep sea: Have we underestimated the importance of land-detached canyons?
- A study of rolling contact fatigue in electric vehicles (EVs)
- Acoustic monitoring of forest exploitation to establish community perspectives of sustainable hunting
- Acoustic sensing and characterisation of soil organic matter
- Advancing intersectional geographies of diaspora-led development in times of multiple crises
- Aero engine fan wake turbulence – Simulation and wind tunnel experiments
- Against Climate Change (DACC): improving the estimates of forest fire smoke emissions
- All-in-one Mars in-situ resource utilisation (ISRU) system and life-supporting using non-thermal plasma
- An electromagnetic study of the continent-ocean transition southwest of the UK
- An investigation of the relationship between health, home and law in the context of poor and precarious housing, and complex and advanced illness
- Antibiotic resistance genes in chalk streams
- Being autistic in care: Understanding differences in care experiences including breakdowns in placements for autistic and non-autistic children
- Biogeochemical cycling in the critical coastal zone: Developing novel methods to make reliable measurements of geochemical fluxes in permeable sediments
- Bloom and bust: seasonal cycles of phytoplankton and carbon flux
- British Black Lives Matter: The emergence of a modern civil rights movement
- Building physics for low carbon comfort using artificial intelligence
- Business studies and management: accounting
- Business studies and management: banking and finance
- Business studies and management: decision analytics and risk
- Business studies and management: digital and data driven marketing
- Business studies and management: human resources (HR) management and organisational behaviour
- Business studies and management: strategy, innovation and entrepreneurship
- Carbon storage in reactive rock systems: determining the coupling of geo-chemo-mechanical processes in reactive transport
- Cascading hazards from the largest volcanic eruption in over a century: What happened when Hunga Tonga-Hunga Ha’apai erupted in January 2022?
- Characterisation of cast austenitic stainless steels using ultrasonic backscatter and artificial intelligence
- Climate Change effects on the developmental physiology of the small-spotted catshark
- Climate at the time of the Human settlement of the Eastern Pacific
- Collaborative privacy in data marketplaces
- Compatibility of climate and biodiversity targets under future land use change
- Cost of living in modern and fossil animals
- Creative clusters in rural, coastal and post-industrial towns
- Deep oceanic convection: the outsized role of small-scale processes
- Defect categories and their realisation in supersymmetric gauge theory
- Defining the Marine Fisheries-Energy-Environment Nexus: Learning from shocks to enhance natural resource resilience
- Design and fabrication of next generation optical fibres
- Developing a practical application of unmanned aerial vehicle technologies for conservation research and monitoring of endangered wildlife
- Development and evolution of animal biomineral skeletons
- Development of all-in-one in-situ resource utilisation system for crewed Mars exploration missions
- Ecological role of offshore artificial structures
- Effect of embankment and subgrade weathering on railway track performance
- Efficient ‘whole-life’ anchoring systems for offshore floating renewables
- Electrochemical sensing of the sea surface microlayer
- Engagement with nature among children from minority ethnic backgrounds
- Enhancing UAV manoeuvres and control using distributed sensor arrays
- Ensuring the Safety and Security of Autonomous Cyber-Physical Systems
- Environmental and genetic determinants of Brassica crop damage by the agricultural pest Diamondback moth
- Estimating marine mammal abundance and distribution from passive acoustic and biotelemetry data
- Evolution of symbiosis in a warmer world
- Examining evolutionary loss of calcification in coccolithophores
- Explainable AI (XAI) for health
- Explaining process, pattern and dynamics of marine predator hotspots in the Southern Ocean
- Exploring dynamics of natural capital in coastal barrier systems
- Exploring the mechanisms of microplastics incorporation and their influence on the functioning of coral holobionts
- Exploring the potential electrical activity of gut for healthcare and wellbeing
- Exploring the trans-local nature of cultural scene
- Facilitating forest restoration sustainability of tropical swidden agriculture
- Faulting, fluids and geohazards within subduction zone forearcs
- Faulting, magmatism and fluid flow during volcanic rifting in East Africa
- Fingerprinting environmental releases from nuclear facilities
- Flexible hybrid thermoelectric materials for wearable energy harvesting
- Floating hydrokinetic power converter
- Glacial sedimentology associated subglacial hydrology
- Green and sustainable Internet of Things
- How do antimicrobial peptides alter T cell cytokine production?
- How do calcifying marine organisms grow? Determining the role of non-classical precipitation processes in biogenic marine calcite formation
- How do neutrophils alter T cell metabolism?
- How well can we predict future changes in biodiversity using machine learning?
- Hydrant dynamics for acoustic leak detection in water pipes
- If ‘Black Lives Matter’, do ‘Asian Lives Matter’ too? Impact trajectories of organisation activism on wellbeing of ethnic minority communities
- Illuminating luciferin bioluminescence in dinoflagellates
- Imaging quantum materials with an XFEL
- Impact of neuromodulating drugs on gut microbiome homeostasis
- Impact of pharmaceuticals in the marine environment in a changing world
- Improving subsea navigation using environment observations for long term autonomy
- Information theoretic methods for sensor management
- Installation effect on the noise of small high speed fans
- Integrated earth observation mapping change land sea
- Interconnections of past greenhouse climates
- Investigating IgG cell depletion mechanisms
- Is ocean mixing upside down? How mixing processes drive upwelling in a deep-ocean basin
- Landing gear aerodynamics and aeroacoustics
- Lightweight gas storage: real-world strategies for the hydrogen economy
- Machine learning for multi-robot perception
- Machine learning for multi-robot perception
- Marine ecosystem responses to past climate change and its oceanographic impacts
- Mechanical effects in the surf zone - in situ electrochemical sensing
- Microfluidic cell isolation systems for sepsis
- Migrant entrepreneurship, gender and generation: context and family dynamics in small town Britain
- Miniaturisation in fishes: evolutionary and ecological perspectives
- Modelling high-power fibre laser and amplifier stability
- Modelling soil dewatering and recharge for cost-effective and climate resilient infrastructure
- Modelling the evolution of adaptive responses to climate change across spatial landscapes
- Nanomaterials sensors for biomedicine and/or the environment
- New high-resolution observations of ocean surface current and winds from innovative airborne and satellite measurements
- New perspectives on ocean photosynthesis
- Novel methods of detecting carbon cycling pathways in lakes and their impact on ecosystem change
- Novel technologies for cyber-physical security
- Novel transparent conducting films with unusual optoelectronic properties
- Novel wavelength fibre lasers for industrial applications
- Ocean circulation and the Southern Ocean carbon sink
- Ocean influence on recent climate extremes
- Ocean methane sensing using novel surface plasmon resonance technology
- Ocean physics and ecology: can robots disentangle the mix?
- Ocean-based Carbon Dioxide Removal: Assessing the utility of coastal enhanced weathering
- Offshore renewable energy (ORE) foundations on rock seabeds: advancing design through analogue testing and modelling
- Optical fibre sensing for acoustic leak detection in buried pipelines
- Optimal energy transfer in nonlinear systems
- Optimal energy transfer in nonlinear systems
- Optimizing machine learning for embedded systems
- Oxidation of fossil organic matter as a source of atmospheric CO2
- Partnership dissolution and re-formation in later life among individuals from minority ethnic communities in the UK
- Personalized multimodal human-robot interactions
- Preventing disease by enhancing the cleaning power of domestic water taps using sound
- Quantifying riparian vegetation dynamics and flow interactions for Nature Based Solutions using novel environmental sensing techniques
- Quantifying the response and sensitivity of tropical forest carbon sinks to various drivers
- Quantifying variability in phytoplankton electron requirements for carbon fixation
- Resilient and sustainable steel-framed building structures
- Resolving Antarctic meltwater events in Southern Ocean marine sediments and exploring their significance using climate models
- Robust acoustic leak detection in water pipes using contact sound guides
- Silicon synapses for artificial intelligence hardware
- Smart photon delivery via reconfigurable optical fibres
- The Gulf Stream control of the North Atlantic carbon sink
- The Mayflower Studentship: a prestigious fully funded PhD studentship in bioscience
- The calming effect of group living in social fishes
- The duration of ridge flank hydrothermal exchange and its role in global biogeochemical cycles
- The evolution of symmetry in echinoderms
- The impact of early life stress on neuronal enhancer function
- The oceanic fingerprints on changing monsoons over South and Southeast Asia
- The role of iron in nitrogen fixation and photosynthesis in changing polar oceans
- The role of singlet oxygen signaling in plant responses to heat and drought stress
- Time variability on turbulent mixing of heat around melting ice in the West Antarctic
- Triggers and Feedbacks of Climate Tipping Points
- Uncovering the drivers of non-alcoholic fatty liver disease progression using patient derived organoids
- Understanding recent land-use change in Snowdonia to plan a sustainable future for uplands: integrating palaeoecology and conservation practice
- Understanding the role of cell motility in resource acquisition by marine phytoplankton
- Understanding the structure and engagement of personal networks that support older people with complex care needs in marginalised communities and their ability to adapt to increasingly ‘digitalised’ health and social care
- Unpicking the Anthropocene in the Hawaiian Archipelago
- Unraveling oceanic multi-element cycles using single cell ionomics
- Unravelling southwest Indian Ocean biological productivity and physics: a machine learning approach
- Using acoustics to monitor how small cracks develop into bursts in pipelines
- Using machine learning to improve predictions of ocean carbon storage by marine life
- Vulnerability of low-lying coastal transportation networks to natural hazards
- X-ray imaging and property characterisation of porous materials
- Funding your research degree
- How to apply for a PhD or research degree
- How to make a PhD enquiry
- Support while studying your PhD or research degree
- Exchanges and studying abroad
- Undergraduate study
-
Tuition fees, funding and scholarships
- Fee status
- Scholarships
- Undergraduate funding options
-
Postgraduate funding options
-
Postgraduate scholarships
- Black Futures Postgraduate Research Scholarships (Environmental and Life Sciences)
- Black Futures scholarship
- China Excellence Scholarship
- GREAT Scholarships 2025 – Egypt
- GREAT Scholarships 2025 – France
- GREAT Scholarships 2025 – Ghana
- Horizon Europe fee waiver
- India Excellence Scholarship
- Nigeria Excellence Scholarship
- Nursing Global Impact Scholarship (Child Nursing and Mental Health Nursing)
- Postgraduate Taught Diversity Scholarship (Environmental and Life Sciences)
- Social Impact Scholarships
- Southampton Business School (MSc) Dean Scholarship (UK)
- Southampton Faculty of Medicine PGT Talent Scholarship
- Southampton History Patricia Mather and Helen Patterson Scholarship
- Southampton MA Holocaust scholarships
- Southampton Philosophy David Humphris-Norman Scholarship
- Southampton Philosophy MA Scholarship
- Southampton Photonics Impact Scholarship
- Southampton UK Alumni Music Scholarship
- Thailand Excellence Scholarship
- The National Institute for Health and care Research South Central INSIGHT Programme
- The South Coast Doctoral Training Partnership Social Science PhD Studentships
- Vietnam Excellence Scholarship
- Winchester School of Art Inclusive Futures Scholarship
- Spärck AI Scholarship
-
Postgraduate scholarships
-
International funding options
-
Scholarships for international students
- Engineering Global Talent Scholarship
- Higher Education Scholarships for Palestinians - HESPAL
- Medical Technology, Innovation and Design Master’s Scholarship
- Merit scholarships for international undergraduates
- Presidential bursaries
- Winchester School of Art Postgraduate Global Talent Scholarship
- Becas Chile Scholarship
- Chevening Scholarships
- China Scholarship Council Scholarships
- COLFUTURO Scholarships
- Commonwealth Distance Learning Scholarships
- Commonwealth Master's Scholarships
- Commonwealth PhD Scholarships
- Commonwealth PhD Scholarships for high income countries
- Commonwealth Shared Scholarships
- Excellence Scholarship
- FIDERH Scholarships
- Southampton Education Civic Scholarship
- Fulbright Awards
- Southampton Ageing and Gerontology Talent Scholarship
- Southampton Teachers' Postgraduate Scholarship
- FUNED Scholarships
- Great Scholarships 2024 – Mexico
- Great Scholarships 2024 – Nigeria
- Marshall Scholarship
- Saïd Foundation Scholarships
- Southampton Canadian Prestige Scholarship for Law
- Xiamen University PhD Scholarships
- GREAT scholarships 2026 – Indonesia
-
Scholarships for international students
- External funding opportunities
- Short courses
- Lunchtime evening and weekend courses
- Clearing
- Summer schools
- Get a prospectus
- Student life
-
Research
- Our impact
- Research projects
- Research areas
- Research facilities
- Collaborate with us
-
Institutes, centres and groups
- Active Living
- Advanced Fibre Applications
- Advanced Laser Laboratory
- Advanced Project Management Research Centre
- Antibody and Vaccine Group
- Astronomy Group
- Autism Community Research Network @ Southampton (ACoRNS)
- Bioarchaeology and Osteoarchaeology at Southampton (BOS)
- Bladder and Bowel Management
- Cell and Developmental Biology
- Centre for Defence and Security Research
- Centre for Developmental Origins of Health and Disease
- Centre for Digital Finance
- Centre for Eastern European and Eurasian Studies (CEEES)
- Centre for Empirical Research in Finance and Banking (CERFIB)
- Centre for Geometry, Topology, and Applications
- Centre for Global Health and Policy (GHaP)
- Centre for Green Maritime Innovation (cGMI)
- Centre for Health Technologies
- Centre for Healthcare Analytics
- Centre for Human Development, Stem Cells and Regeneration
- Centre for Imperial and Postcolonial Studies
- Centre for Inclusive and Sustainable Entrepreneurship and Innovation (CISEI)
- Centre for International Film Research (CIFR)
- Centre for International Law and Globalisation
- Centre for Internet of Things and Pervasive Systems
- Centre for Justice Studies
- Centre for Linguistics, Language Education and Acquisition Research
- Centre for Machine Intelligence
- Centre for Maritime Archaeology
- Centre for Medieval and Renaissance Culture (CMRC)
- Centre for Political Ethnography (CPE)
- Centre for Research in Accounting, Accountability and Governance
- Centre for Research on Work and Organisations
- Centre for Resilient Socio-Technical Systems
- Centre for Transnational Studies
- Child and Adolescent Research Group
- Clinical Ethics, Law and Society (CELS)
- Clinical Legal Education
- Computational Nonlinear Optics
- Cyber Security Academy
- Data Science Group
- Digital Oceans
- EPSRC and MOD Centre for Doctoral Training in Complex Integrated Systems for Defence and Security
- Economic Theory and Experimental Economics
- Economy, Society and Governance
- Electrical Power Engineering
- Environmental Hydraulics
- Gas Photonics in Hollow Core Fibres
- Geochemistry
- Global Health (Demography)
- Global Health Community of Practice
- Gravity group
- High Power Fibre Lasers
- Hollow Core Fibre
- Human Genetics and Genomic Medicine
- Infection
- Infrastructure Group
- Institute of Developmental Sciences
- Institute of Maritime Law (IML)
- Integrated Photonic Devices
- Interdisciplinary Musculoskeletal Health
- International Centre for Ecohydraulics Research (ICER)
- Language Assessment and Testing Unit (LATU)
- Laser-Direct-Write (LDW) Technologies for Biomedical Applications
- Law and Technology Centre
- Long Term Conditions
- Magnetic Resonance
- Mathematical Modelling
- Medicines Management
- Molecular and Precision Biosciences
- Multiwavelength Accretion and Astronomical Transients
- National Biofilms Innovation Centre (NBIC)
- National Centre for Research Methods
- National Infrastructure Laboratory
- Nature-Based Ocean Solutions
- Nonlinear Semiconductor Photonics
- Ocean Perception Group
- Operational Research
- Optical Engineering and Quantum Photonics Group
- Paediatrics and Child Health - Clinical and Experimental Sciences
- People, Property, Community
- Photonic Systems, Circuits and Sensors Group
- Physical Optics
- Primary Care Research Centre
- Quantum, Light and Matter Group
- Silica Fibre Fabrication
- Silicon Photonics
- Skin Sensing Research Group
- Southampton Ethics Centre
- Southampton Health Technology Assessments Centre (SHTAC)
- Southampton High Energy Physics group
- Southampton Imaging
- Southampton Theory Astrophysics and Gravity (STAG) Research Centre
- Stefan Cross Centre for Women, Equality and Law
- String theory and holography
- The India Centre for Inclusive Growth and Sustainable Development
- The Parkes Institute
- Tony Davies High Voltage Laboratory
- Ultrafast X-ray Group
- Vision Science
- WSA Exchange
- Work Futures Research Centre (WFRC)
- Support for researchers
- Faculties, schools and departments
- Interdisciplinary research
- Find people and expertise
- Research jobs
- Business
- Global
- About
- Visit
- Alumni
- Departments
- News
- Events
- Contact